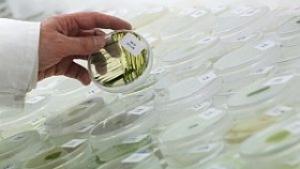
Японски учени получиха топлоустойчива биопластмаса от водорасли

Технологии
Актуални новини от Технологии. Посетете нашата секция с новини от Технологии Сега!
10.01.2013
Вероятността Апофис да ни удари след 23 г. е голяма, смятат от обсерваторията в Рожен
Голяма е вероятността астероидът Апофис, който премина на 14 милиона километра от Земята, ...
10.01.2013
Японски учени получиха топлоустойчива биопластмаса от водорасли
Японски учени за първи път получиха топлоустойчива биопластмаса от едноклетъчното ...
10.01.2013
Компания се готви да достави хора на Марс… без да ги връща обратно
Звучи странно, но е съвсем сериозно. Компанията е холандска, казва се Mars-One и счита, че ...
10.01.2013
Нито един от известните астероиди няма да застраши Земята през 2013 година
Руското министерство на извънредните ситуации не прогнозира повишен риск през 2013 ...
09.01.2013
Индия проведе успешни изпитания на свръсхзвукова крилата ракета "Брамос"
Индия проведе успешни изпитания на свръсхзвукова крилата ракета "Брамос", предаде ...
09.01.2013
Показаха 20-инчов таблет с Ultra HD резолюция
Какво се случва по време на форума CES 2013, който в момента се провежда в Лас Вегас - актуални ...
09.01.2013
Безплатен интернет вече и извън нюйоркските паркове
Интернет гигантът Google обяви във вторник, че пуска съвместно с местен партньор безжичен ...
09.01.2013
Астероидът Апофис ще профучи край Земята
Потенциално застрашаващият Земята астероид Апофис ще прелети днес в 13,43 ч. на около ...
08.01.2013
Британски синоптици твърдят, че Земята не е застрашена от рязко затопляне
Метеорологичната служба на Великобритания предвижда климатът в близките четири години ...
08.01.2013
Sony представи първия в света водоустойчив телефон
Японската компания Sony представи първия в света водоустойчив мобилен телефон, който ...
08.01.2013
Астрономи са открили милиарди подобни на Земята планети
Астрономи са открили свидетелства за това, че в нашата галактика има около 17 милиарда ...
08.01.2013
Има ли растения на Марс?
Сред камъните и отломките на червената планета марсоходът "Кюриосити" за първи път ...
08.01.2013
Samsung пуска телевизор за двама зрители
Южнокорейската компания Samsung представи в Лас Вегас нов телевизор, на който двама души ...
07.01.2013
"Доматено хапче" ще бори сърдечни заболявания
Хапче, създадено на основата на домати, може да се окаже ключът за побеждаването на ...
07.01.2013
Учени са създали Т-клетки за борба с ХИВ и рак
Учени от Токийския институт за медицински науки са създали клетки, които може да помогнат ...
07.01.2013
Японски учени заснеха гигантска сепия в дълбините на Тихия океан
Японски учени обявиха, че са успели да заснемат загадъчна гигантска сепия, дълга около ...
04.01.2013
Land Cruiser се наежи за Токио
Тунерите от Wald International обявиха, че са подготвили невероятно агресивен пакет Black Bison ...
04.01.2013
Анонимните хакната сайта на хърватското правителство
Международната хакерска група Анонимните успяла да хакне сайта на хърватското правителство ...
04.01.2013
Метеорит разкрива тайните на Марс
Група учени от университета в Ню Мексико, САЩ, са открили в пустинята Сахара марсиански ...
03.01.2013
Учени твърдят, че са открили ваксина, която временно блокира ХИВ-вируса
Екип испански учени твърдят, че са създали терапевтична ваксина, която временно може ...
03.01.2013
Учени откриха корали на безпрецедентна дълбочина
Австралийски учени, които изследват Големия бариерен риф, са открили за първи път корали ...
03.01.2013
Отломки от „Космос-1484” може да паднат на Земята на 12 януари
Отломки от съветския спътник „Космос-1484", които не са изгорели в плътните слоеве на ...
02.01.2013
Лаптопите заместват тетрадките в германските училища
Дъската и тебеширът останаха в миналото. Германските ученици все по-често работят ...
02.01.2013
Sony каза сбогом на PlayStation 2
Гигантът Sony взе решение да сложи край на производството на PlayStation 2, който е най-добре ...
02.01.2013
Русия планира до 2020 г. да започне строителството на арктически кораби
Строителството на кораби за ВМС на Русия за решаването на задачи в Арктика ще започне ...
02.01.2013
Bentley разкри цифрите за най-бързото кабрио
Дванадесет дни преди началото на автомобилния салон в Детройт Bentley разкри пълните ...
02.01.2013
Ново поколение телевизори
Корейската LG Electronics пусна в продажба своите най-нови телевизори, използващи следващо ...
30.12.2012
Китай пусна метро под река
В източния китайски град Ухан бе пусната в експлоатация първата метролиния под река ...
30.12.2012
Instagram с класация на най-популярните места в света през 2012-а
Най-често потребителите на услугата за обработка и споделяне на снимки Instagram са се ...
28.12.2012
Китай затегна контрола върху интернет
Китайският парламент одобри предложените от правителството мерки за затягане на контрола ...
28.12.2012
Северна Корея е почти готова за нов ядрен опит
Северна Корея е отстранила щетите, причинени от наводненията в нейния ядрен център ...
28.12.2012
Германците не се грижат за колите си, твърдят експерти
Германците, изпитващи финансови затруднения, харчат по-малко пари за поддръжка на ...
28.12.2012
Популярността на електронните книги в САЩ расте
Популярността на електронните книги в САЩ нараства, като близо една четвърт от американските ...
27.12.2012
Горещи джаджи
Горещите джаджи на предстоящата 2013, таблетът Iconia W700 на Acer и драмата около Булсатком ...
27.12.2012
Mercedes-Benz CLS получава битурбо V6
Mercedes-Benz CLS ще се обзаведе с нов 3,0-литров битурбо V6 с макс. мощност 333 к.с. и въртящ момент ...
27.12.2012
Учени разгадаха генома на домашната коза
Международен екип от биолози успя да разгадае генома на домашната коза, което ще помогне ...
27.12.2012
Антарктида се загрявала много бързо
Ледената покривка в западните райони на Антарктида се загрява много повече от останалата ...
26.12.2012
Видеоиграчките трябва да са с напрежение до 24V
Видеоиграчките за деца, които се управляват с джойстик или клавиатура, трябва да имат ...
23.12.2012
Информират еврокомисаря за новите технологии по случая Булсатком-bTV
Представители на Асоциацията на потребителите на телекомуникационни услуги са изпратили ...
22.12.2012
Кабелни оператори спират излъчването на програмите на bТV Media Group
Разпространението на програмите на bТV Media Group ще бъде прекратявано в мрежите на кабелните ...